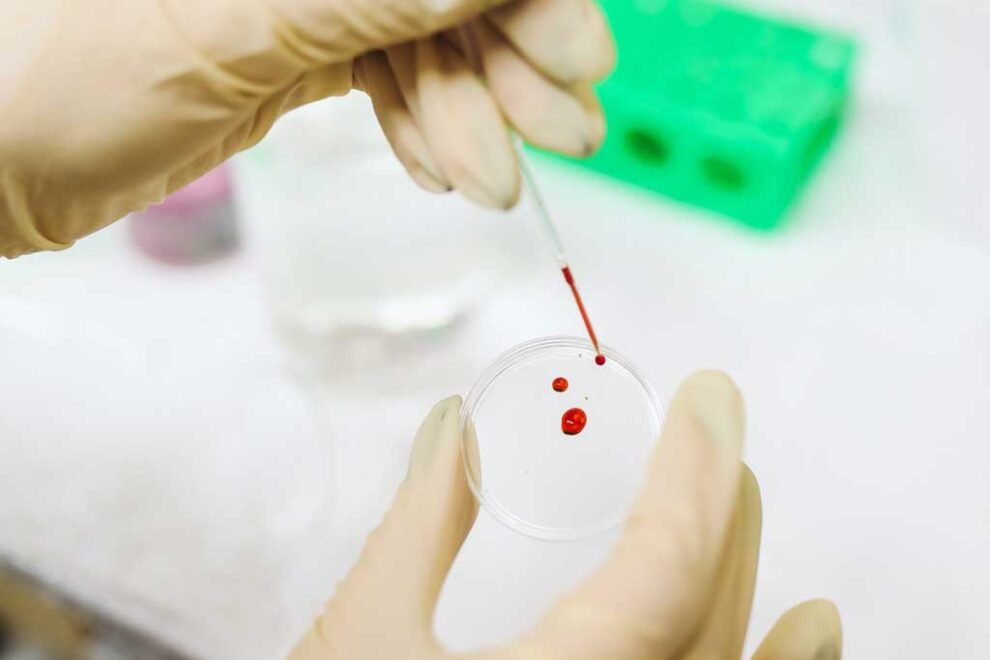
le-infiltrazioni-con-i-fattori-di-crescita

Frattura prossimale dell’omero
Frattura prossimale dell’omero. La frattura prossimale dell’omero è una lesione comune che coinvolge la parte superiore dell’osso dell’omero, la quale è collegata all’articolazione della spalla. Questo tipo di frattura può verificarsi…